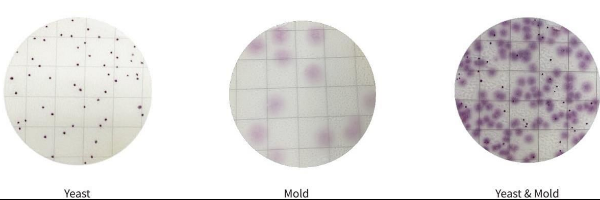
MicroFast Yeast & Mold Count Plate

Описание
Подложка MicroFast Yeast & Mold Count Plate для дрожжей и плесеней (YM) представляет собой простую и готовую систему с питательной средой, в которой используются инновационные технологии, такие как системы быстрой диффузии и микробное окрашивание нового поколения, для достижения быстрого распределения образца и интерпретации колоний, что значительно повышает эффективность анализа в лаборатории.
Подложка содержит готовую питательную среду, гель растворимый в холодной воде и индикатор. Подложка предназначена для подсчета дрожжей и плесеней в пищевых продуктах и пробах окружающей среды.
Особенности применения MicroFast Yeast & Mold Count Plate
- Инкубируйте подложки MicroFast в горизонтальном положении пленкой вверх стопками не более 20 штук.
- Инкубация при 28 ± 1 ° C в течение 48 ± 2 ч для дрожжей и 72 ± 2 ч для плесеней
- Колонии дрожжей мелкие, четко очерченные, однородного цвета, фиолетово-красного цвета.
- Колонии плесеней крупные с размытыми краями, цвет неравномерный, интенсивность окраски колоний от светло-розового до фиолетово-красного цвета.
- Высокие концентрации колоний — вся зона роста обесцвечивается
- Для начала необходимо подготовить образец, который будет анализироваться.
- Затем образец наносится на поверхность подложки и оставляется на инкубацию при оптимальной температуре.
- После определенного времени можно оценить количество дрожжей и плесневых грибов по количеству образовавшихся колоний.
По сравнению с традиционными чашками Агар-Петри:
- Экономия места – Компактная конструкция снижает потребность в хранении.
- Сокращаются лабораторные расходы – не требуется подготовка среды и меньшее количество необходимого оборудования.
- Повышается экономическая эффективность – Упрощается рабочий процесс, повышается производительность.
- Сокращается время тестирования – результаты получаются в два раза быстрее по сравнению со стандартными чашками с агаром.
Компания Meizheng Bio-Tech Co., Ltd сертифицирована Международной организацией по стандартизации (ISO) 9001 для проектирования и производства.
Подложка MicroFast для дрожжей и плесеней (YM) не тестировалась со всеми пищевыми продуктами, пищевыми процессами, протоколами испытаний или со всеми возможными штаммами микроорганизмов.






























